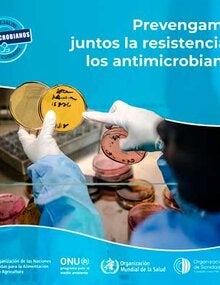
Colección de postales para redes sociales: Prevengamos juntos la RAM

- Inicio
- Temas
- Países
- Recursos
- Noticias
-
Acerca de
-
- Organigrama
- Situación de las contribuciones de los Estados Miembros
-
Qué hacemos
- Evidencia e inteligencia para la acción en salud
- Inmunización Integral
- Innovación, Acceso a Medicamentos y Tecnologías Sanitarias
- Prevención, Control y Eliminación de Enfermedades Transmisibles
- Determinantes Sociales y Ambientales para la Equidad en la Salud
- Emergencias en Salud
- Sistemas y servicios de salud
- Enfermedades no Transmisibles y Salud Mental
- Alianzas
- Oficina de Auditoría Interna
- Oficina de investigaciones
-